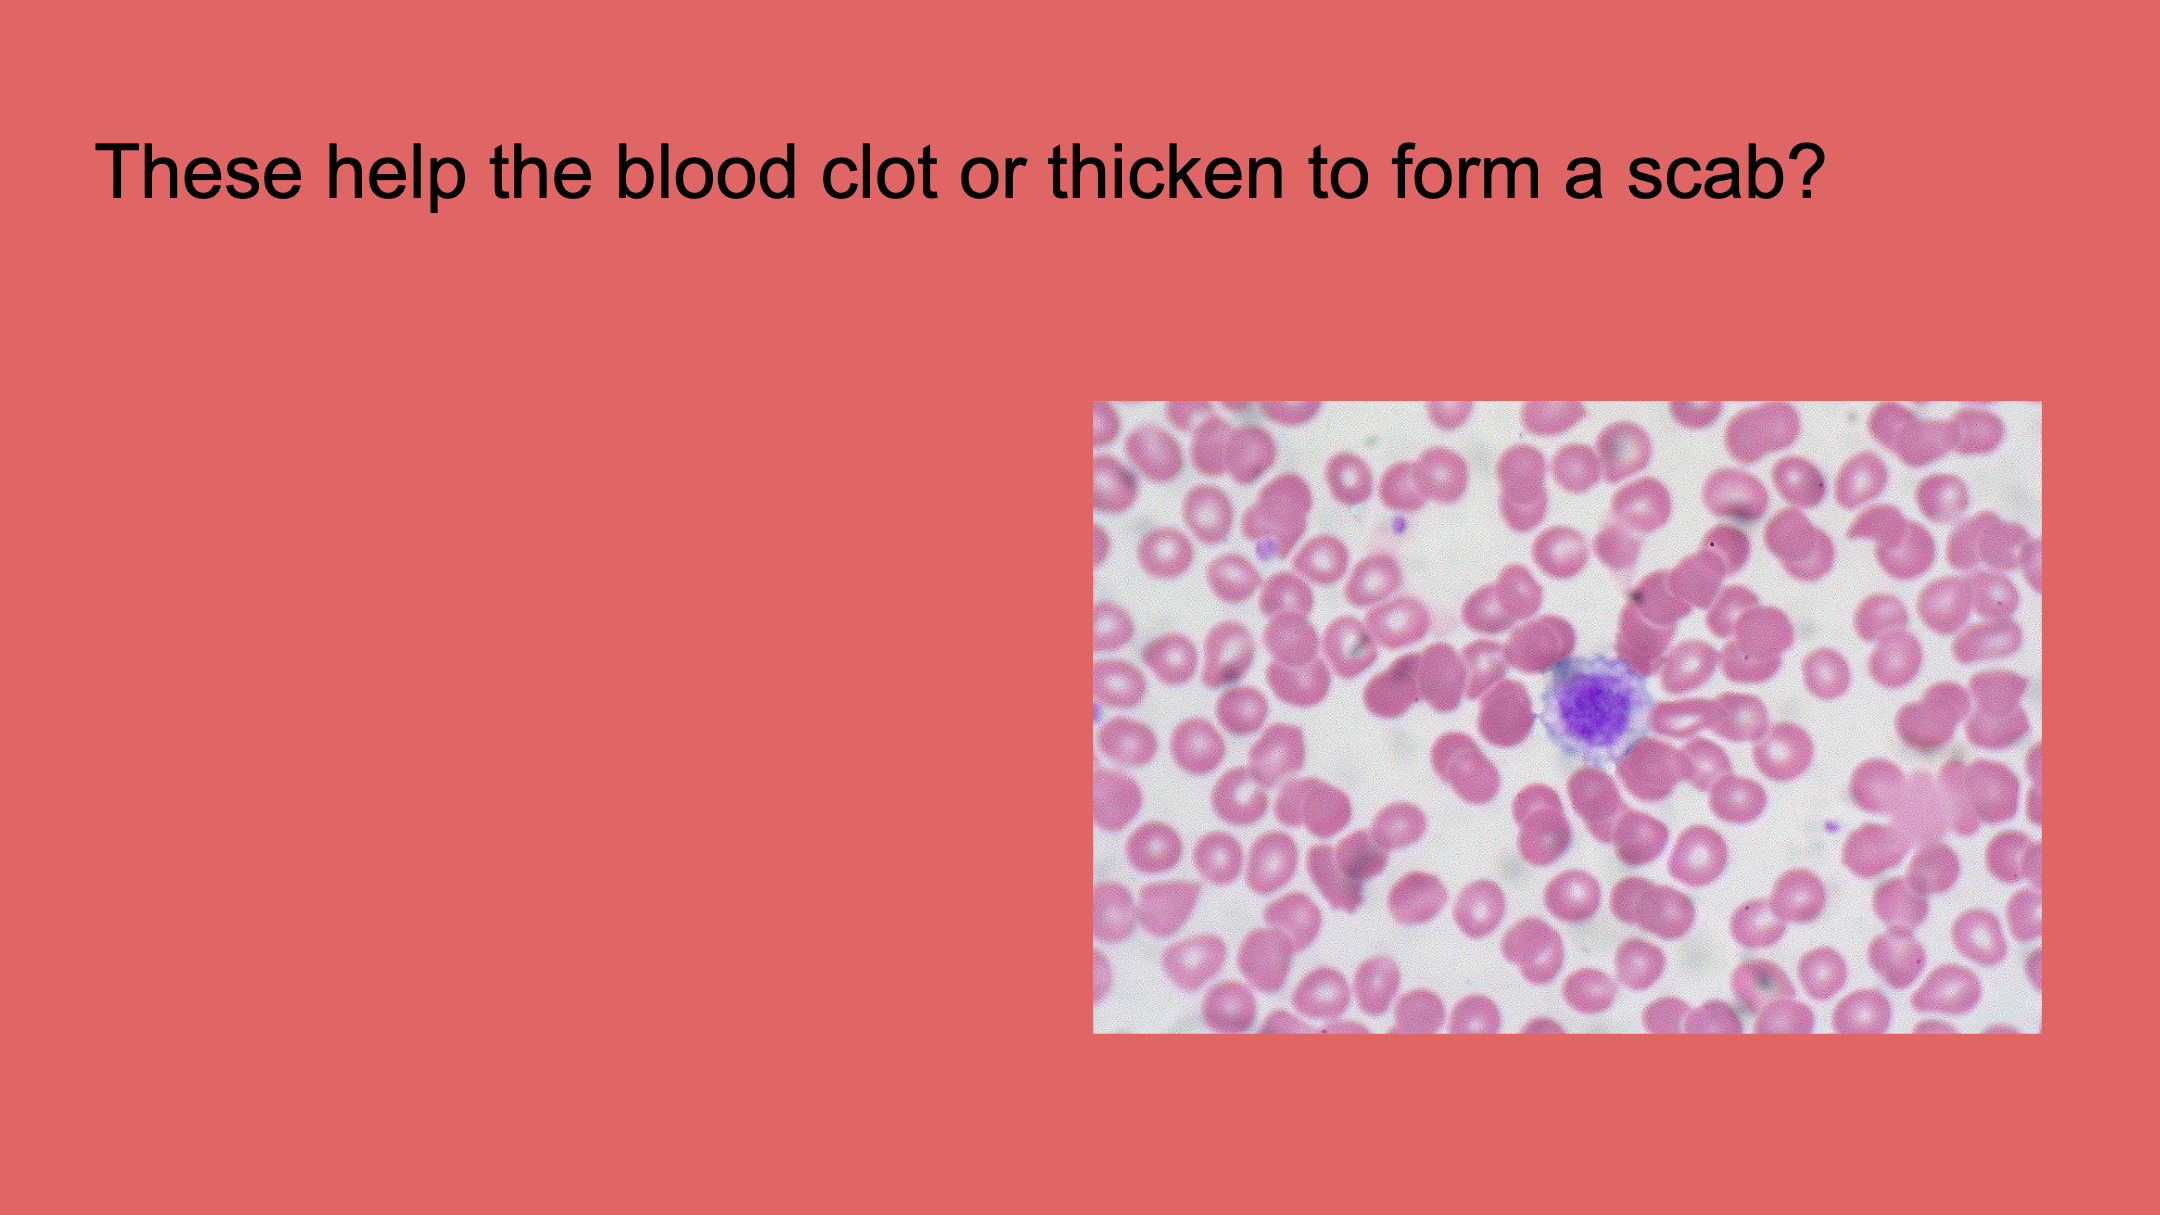
media

Circulatory System Review Snowball
Presentation
•
Physical Ed
•
5th Grade
•
Hard
Nicholas Ottoy
Used 1+ times
FREE Resource
30 Slides • 23 Questions
1
2
Multiple Choice
3
4
Multiple Choice
5
6
Multiple Select
7
8
Multiple Choice
9
10
Multiple Choice
11
12
Multiple Choice
13
14
Multiple Choice
15
16
Multiple Choice
17
18
19
Multiple Choice
20
21
Multiple Choice
22
23
24
25
Multiple Choice
26
27
Multiple Choice
28
29
Multiple Choice
30
31
Fill in the Blank
32
33
Multiple Choice
34
35
Fill in the Blank
36
37
Multiple Choice
38
39
Fill in the Blank
40
41
Fill in the Blank
42
43
Fill in the Blank
44
45
Multiple Choice
46
47
48
Fill in the Blank
49
50
51
52
53
Poll
Show answer
Auto Play
Slide 1 / 53
SLIDE